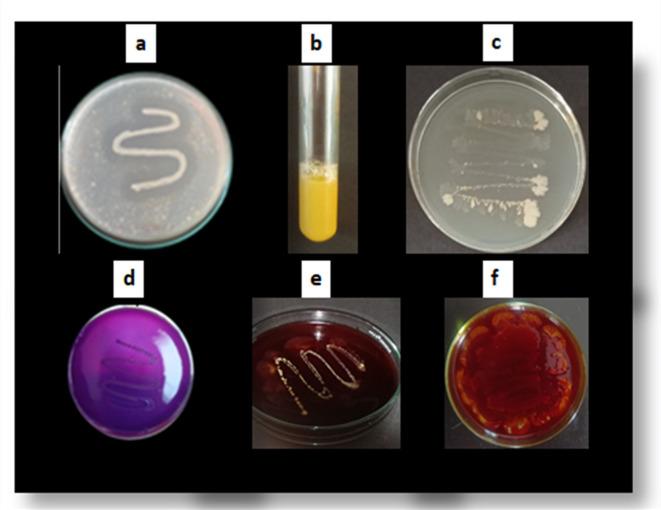
https://cdn.ncbi.nlm.nih.gov/pmc/blobs/ac1d/11698993/c7a6c956cd61/41598_2024_77926_Fig10_HTML.jpg

体外和计算机模拟研究揭示内生解淀粉芽孢杆菌CBMB205对尖孢镰刀菌的新型抗真菌活性。
In vitro and In silico investigation deciphering novel antifungal activity of endophyte Bacillus velezensis CBMB205 against Fusarium oxysporum.
作者信息
R Vibha, Granada Daniela Loaiza, Skariyachan Sinosh, P Ujwal, K Sandesh
机构信息
Department of Biotechnology Engineering, NITTE (Deemed to be University), NMAM Institute of Technology, 574110, Karnataka, India.
Department of Agricultural Science, Jaime Isaza Cadavid Colombian Polytechnic, Medellin, Colombia.
出版信息
Sci Rep. 2025 Jan 3;15(1):684. doi: 10.1038/s41598-024-77926-1.
Endophytes from medicinal plants are potential biocontrol agents against Fusarium oxysporum f. sp. cubense (Foc), which is the causative fungus of banana wilt disease. In the present study, the endophytic bacterium was isolated from Globba racemosa and their antagonistic activities against Foc were studied, and the probable molecular mechanism of antagonism was predicted by molecular docking studies. The 16SrRNA sequencing confirmed the endophytic isolate to be Bacillus velezensis CBMB205 (EG2). The antagonistic activities of the isolates by distortion of fungal hyphae were illustrated in SEM. The probable metabolites present in endophytic isolate were identified by FTIR, suggesting the presence of C-H, CH3 and O-H groups. Two major metabolites such as β-amyrin and dihydroxy octadecenoic acid (DA) were confirmed by LC-MS analysis. Molecular docking studies suggested that these metabolites showed potential binding with chitin synthase 1 and fungal 1,3-glucan synthase of pathogenic fungi. The binding energy (BE) of the molecular interaction between β-amyrin and chitin synthase-1 (CS-1), and 1,3-glucan synthase (1,3-GS) were estimated to be -10.17 kcal/mol and - 9.5 kcal/mol, respectively. The BE of the interaction between β-amyrin and CS-1 and 1,3-GS were determined to be -2.43 kcal/mol and 3.4 kcal/mol, respectively. The current study demonstrated the antagonistic activities of EG2 towards Foc and provided a probable molecular mechanism by in silico studies. The study also provides a potential insight into developing endophytic metabolite-based antifungal agents for various agricultural applications.
药用植物内生菌是防治香蕉枯萎病致病菌尖孢镰刀菌古巴专化型(Foc)的潜在生物防治剂。在本研究中,从总序舞花姜中分离出内生细菌,并研究了它们对Foc的拮抗活性,同时通过分子对接研究预测了可能的拮抗分子机制。16SrRNA测序证实内生分离株为贝莱斯芽孢杆菌CBMB205(EG2)。扫描电子显微镜显示了分离株通过扭曲真菌菌丝发挥的拮抗活性。通过傅里叶变换红外光谱鉴定了内生分离株中可能存在的代谢产物,表明存在C-H、CH3和O-H基团。液相色谱-质谱分析确认了两种主要代谢产物,如β-香树脂醇和二羟基十八碳烯酸(DA)。分子对接研究表明,这些代谢产物与致病真菌的几丁质合酶1和真菌1,3-葡聚糖合酶具有潜在结合能力。β-香树脂醇与几丁质合酶-1(CS-1)和1,3-葡聚糖合酶(1,3-GS)分子相互作用的结合能(BE)估计分别为-10.17千卡/摩尔和-9.5千卡/摩尔。β-香树脂醇与CS-1和1,3-GS相互作用的BE分别确定为-2.43千卡/摩尔和3.4千卡/摩尔。本研究证明了EG2对Foc的拮抗活性,并通过计算机模拟研究提供了可能的分子机制。该研究还为开发用于各种农业应用的基于内生代谢产物的抗真菌剂提供了潜在的见解。